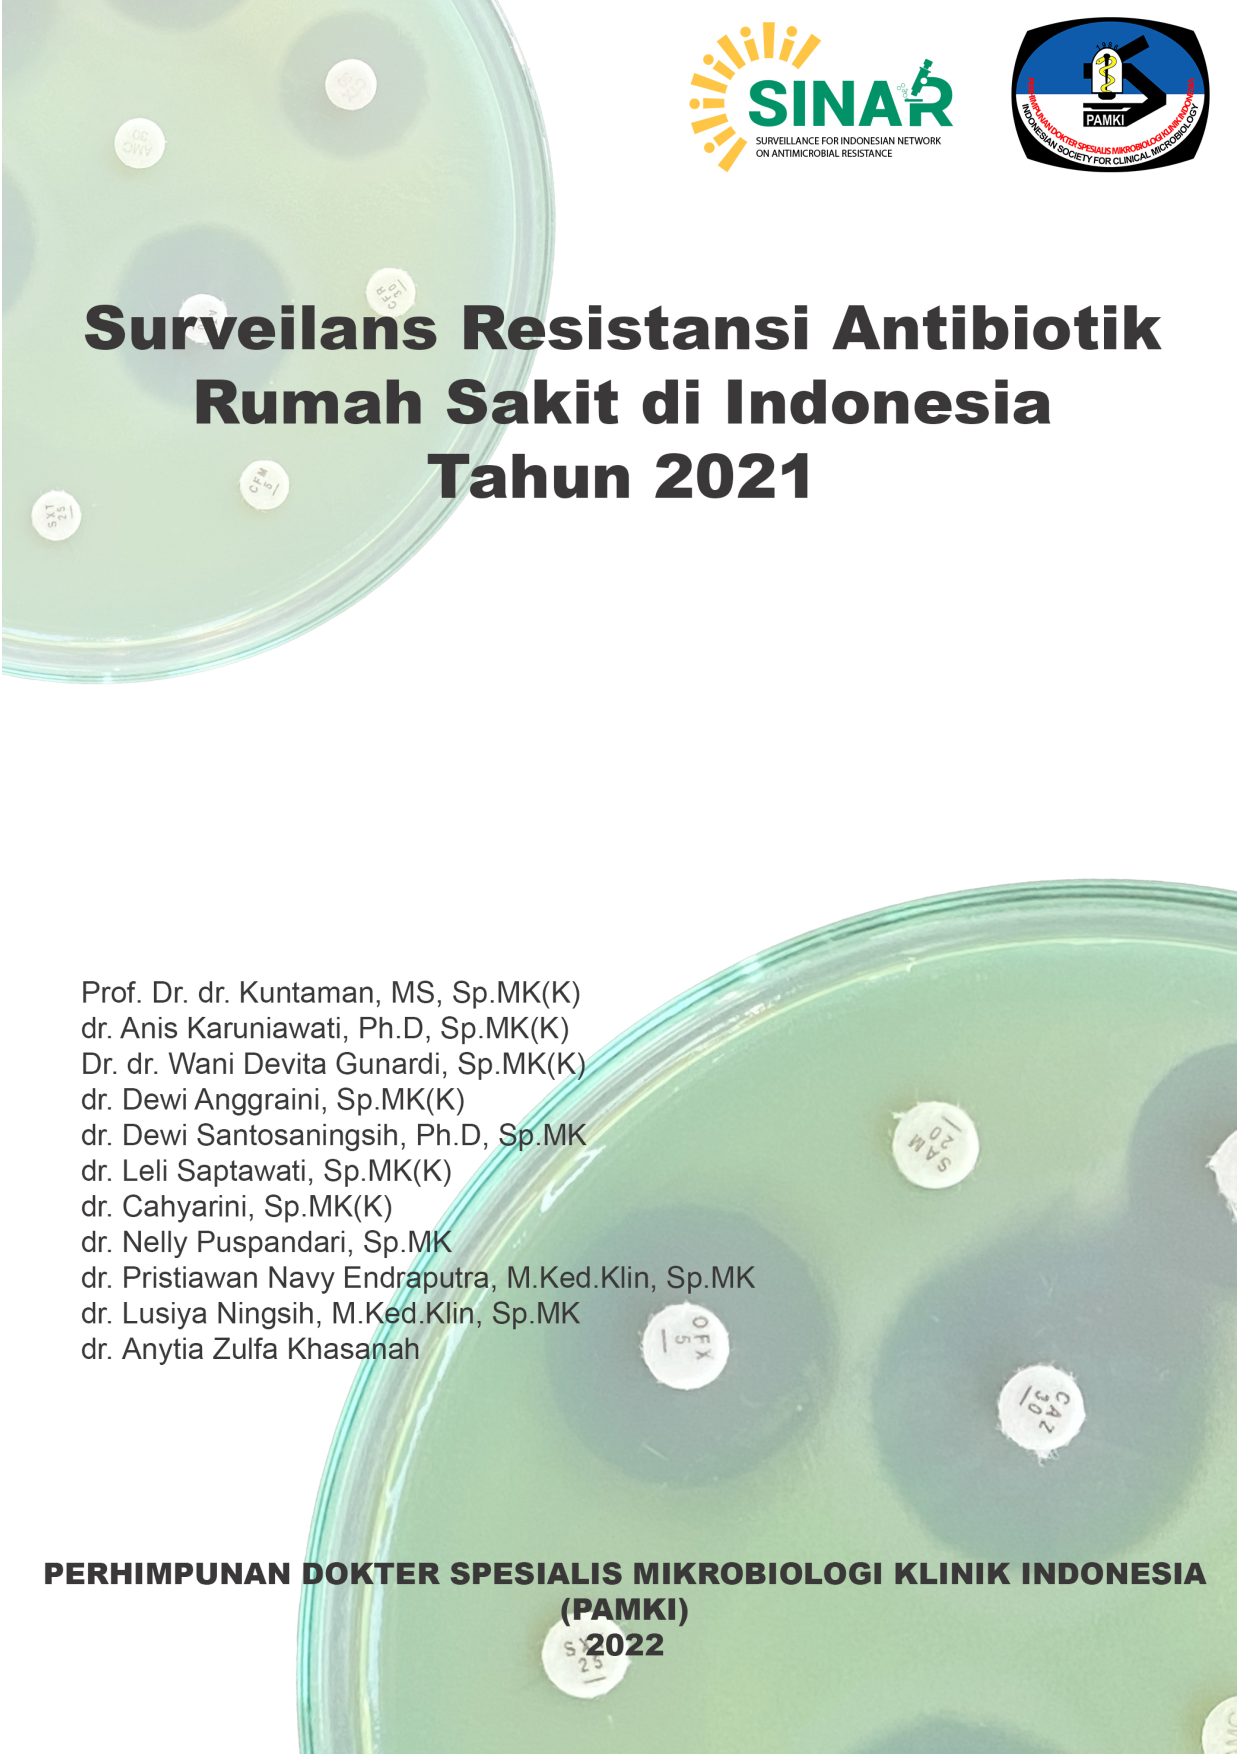

- Version
- Download 16
- File Size 4.67 MB
- File Count 1
- Create Date November 28, 2025
- Last Updated November 28, 2025
- Download
- Home
- Antibiogram 2022 by Specimen
- Antibiogram 2022 by Location
- Antibiogram 2022 by Hospital Type
- Antibiogram 2022 by Region
- Antibiogram Jamur 2022 by Specimen
- Antibiogram Jamur 2022 by Location
- Antibiogram Jamur 2022 by Hospital Type
- Antibiogram WHO Priority Pathogens 2022
- Distribusi berdasarkan Jenis Spesimen
- E. coli 3rd generation cephalosporin resistant
- K. pneumoniae 3rd generation cephalosporin resistant
- E. coli carbapenem resistant
- K. pneumoniae carbapenem resistant
- Pseudomonas aeruginosa carbapenem resistant
- Acinetobacter baumannii-complex carbapenem resistant
- MRSA (Methicilin-resistant Staphylococcus aureus)
- Distribusi WHO Priority Pathogens by Region
- Download
- Home
- Antibiogram 2022 by Specimen
- Antibiogram 2022 by Location
- Antibiogram 2022 by Hospital Type
- Antibiogram 2022 by Region
- Antibiogram Jamur 2022 by Specimen
- Antibiogram Jamur 2022 by Location
- Antibiogram Jamur 2022 by Hospital Type
- Antibiogram WHO Priority Pathogens 2022
- Distribusi berdasarkan Jenis Spesimen
- E. coli 3rd generation cephalosporin resistant
- K. pneumoniae 3rd generation cephalosporin resistant
- E. coli carbapenem resistant
- K. pneumoniae carbapenem resistant
- Pseudomonas aeruginosa carbapenem resistant
- Acinetobacter baumannii-complex carbapenem resistant
- MRSA (Methicilin-resistant Staphylococcus aureus)
- Distribusi WHO Priority Pathogens by Region